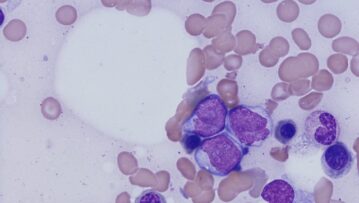
Prescient-Therapeutics-ASX-PTX-study-eradicating-cancer-patients-acute-myeloid-leukemia-AML

- A gross income of $250,000 or more per annum in each of the previous two financial years; or
- Net assets of at least $2.5 million; and
- A verified Qualified Accountant’s certificate given no more than two (2) years ago confirming the Sophisticated Investor status. Please refer to the Corporations Act: Specifically Section 708(08) and Section s761G(7)